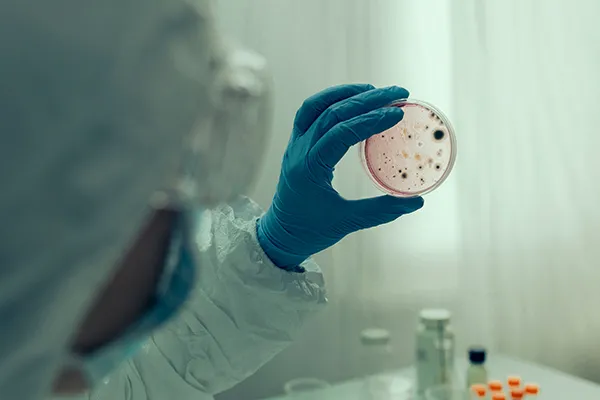
About Image

Supporting evaluation, regulatory execution, and deployment readiness.

Targeting high-accuracy performance benchmarks in cancer and infectious disease detection workflows with AI models.
Support the development of AI-based diagnostic systems using large-scale clinical datasets across oncology, infectious diseases, and point-of-care testing (POCT).
Predictive analytics uses AI to analyze past and real-time data, helping healthcare professionals forecast risks.
Remote monitoring uses AI-powered tools to track patients’ health in real time, enabling early detection of issues.
Virtual health assistants use AI to provide instant medical support, answer patient queries, schedule appointments.
Healthcare automation streamlines administrative and clinical tasks using AI, reducing manual work, minimizing errors.

At the intersection of advanced technology and modern medicine, we build AI-powered solutions that enhance diagnostics, streamline care delivery, and transform patient outcomes.








We bring the power of AI to diverse healthcare domains, enabling precision, automation, and enhanced decision-making across the board.


AI tools for hospitals and specialists that enhance diagnostic accuracy.


Streamlining outpatient services with smart triage, automated reporting.


Accelerating drug discovery and clinical trials with predictive analytics.
An AI prediction is made globally to support faster diagnoses.
Repetitive clinical tasks are handled efficiently by AI.
Massive health data is processed to improve outcomes.

AI-powered tools are transforming care delivery by streamlining workflows, minimizing diagnostic errors, and enhancing treatment personalization. Our platform bridges clinical expertise with data intelligence for measurable impact.